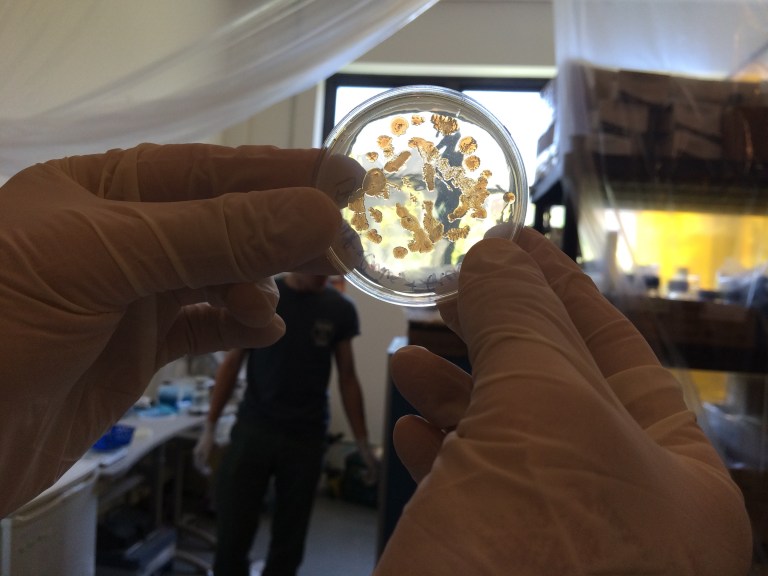
IMG_0401
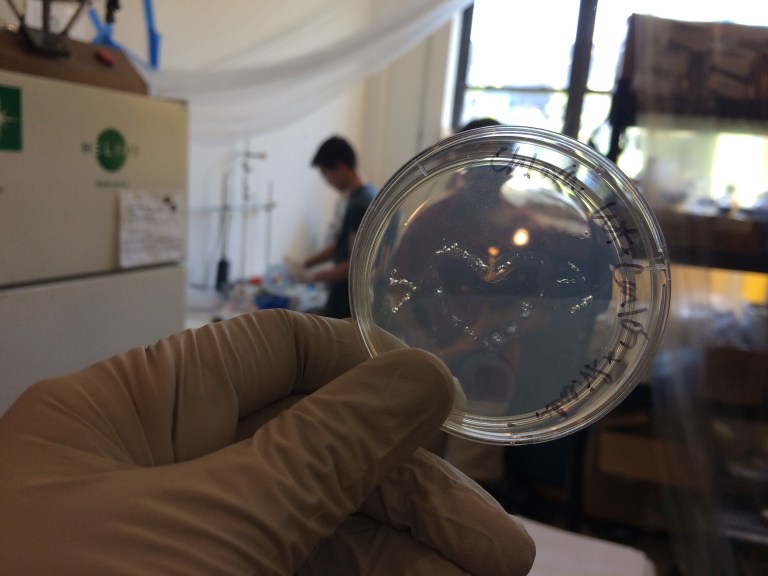
IMG_0410

BricoBio is a DIY Bio group in Montreal, with a biosafety level 1 lab located in Helios Makerspace. WhiteFeather is an incorporating member of BricoBio, and recently participated in a plasmid transformation (with E. coli) workshop led by Kevin Chen.
The two-part workshop included mixing LB with agar and an antibiotic, as well as cultivating E. coli on agar. Six of the cultivated E. coli colonies were mixed with transformation buffer solution and plasmids for antibiotic resistance and red fluorescence. A Synbiota kit was used. Our protocol was only slightly different that the Synbiota protocol. The new, antibiotic resistant (and fluorescent) bacteria solution was then applied to the agar plate with antibiotic.

Results of the experiment: Ultimately, no bacteria grew on the plates, meaning the plasmid transformation process was unsuccessful. A variety of factors were examined. Next experiments to be done will use the CRISPR Cas-9 system.
